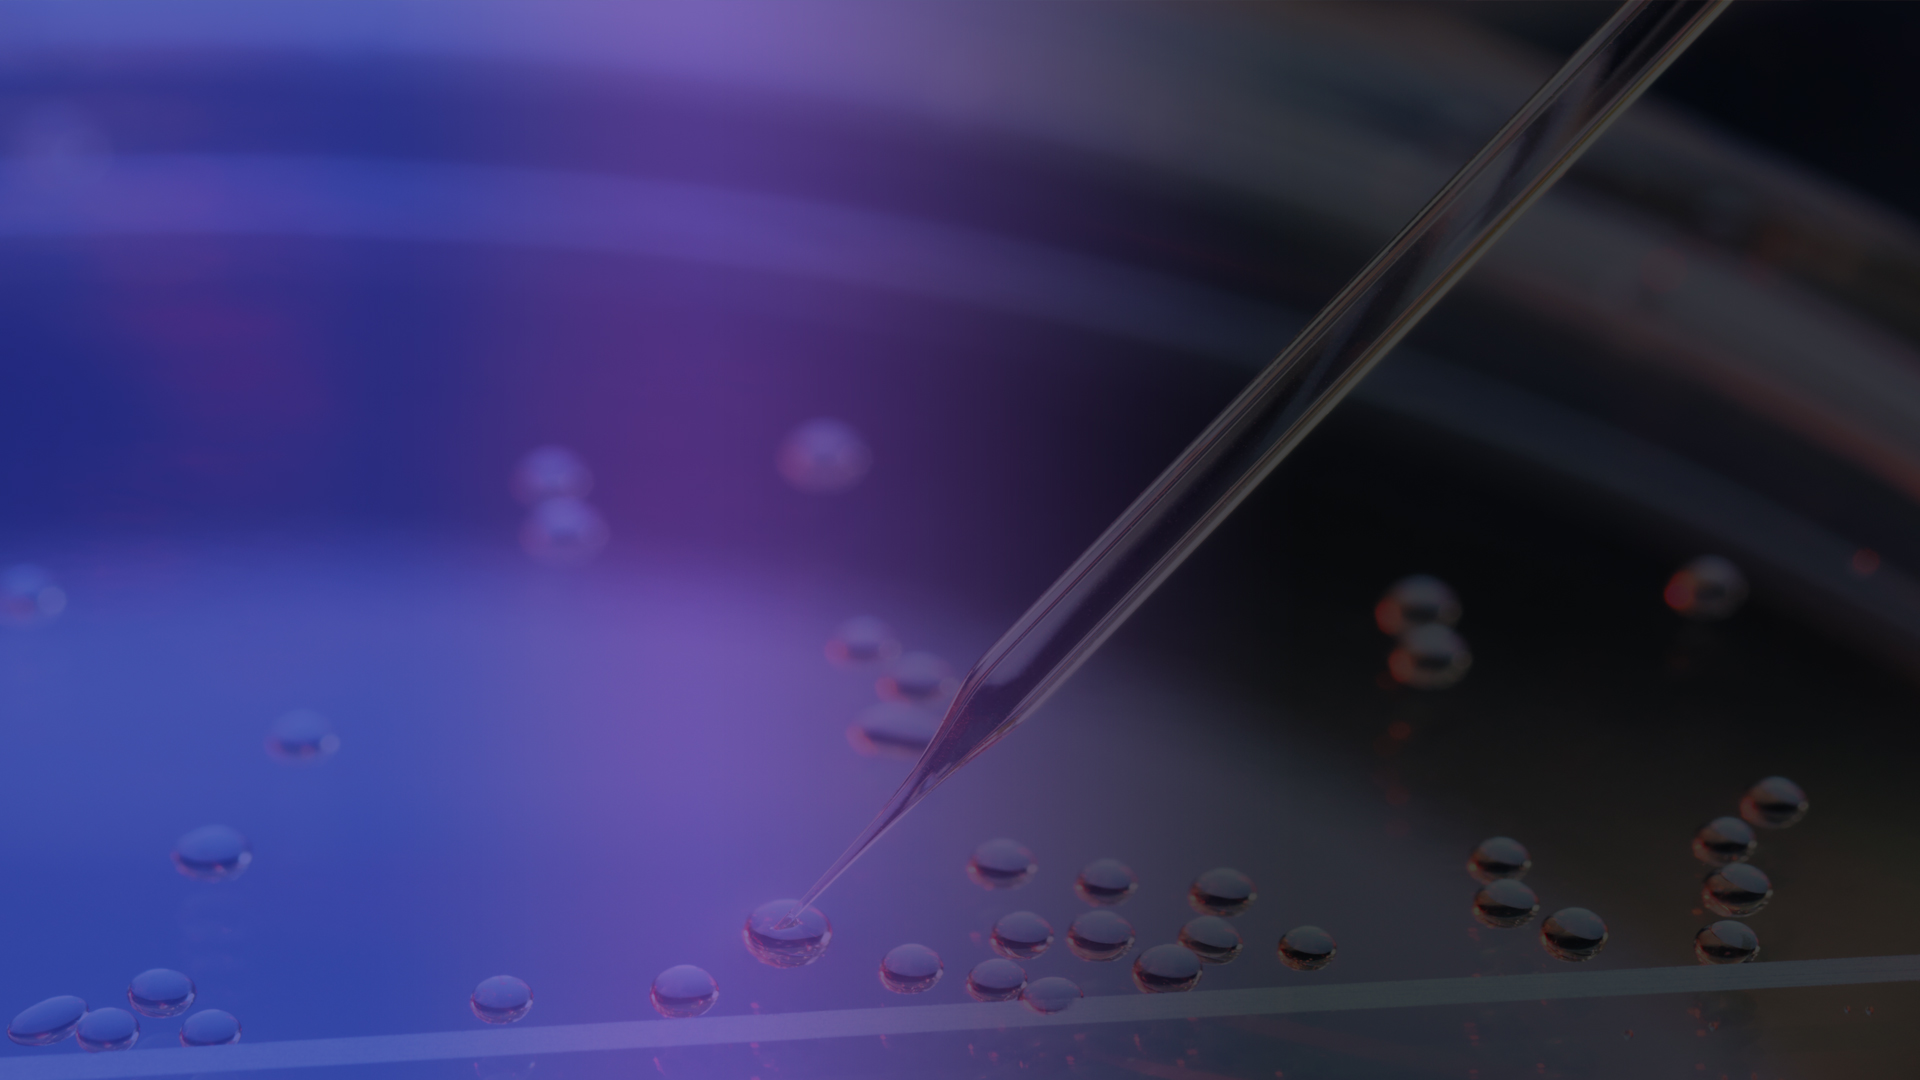
From Models to Patients: Harnessing Pretreated PDX Models for Precision Medicine

FactSheet
Drug Combination Synergy Analysis

FactSheet
Preclinical Biomarker Discovery

On-Demand Webinar
Beyond Exposure: Integrating PK/PD for Translational Predictive Power

FactSheet
Global Specialty Biomarker Laboratory

On-Demand Webinar
Translational In Vitro & In Vivo Models for ADC Therapeutic Development

FactSheet
PBMC Humanized Mouse Models

On-Demand Webinar
Preclinical Drug-Resistant Tumor Models for Cancer Drug Development

FactSheet
Bone Marrow Niche Platform

On-Demand Webinar
Tackling Cancer Drug Resistance with CDX Models

On-Demand Webinar
The Critical Role of Biospecimen Quality in Translational Research

On-Demand Webinar
De-risking CDX Models in Humanized Mice

FactSheet
Cell Line-Derived Xenograft Models

On-Demand Webinar
Beyond Checkpoints: Strategic Use of CDX Models in Emerging IO Therapies

On-Demand Webinar
Translational Biomarker Lab - Unlocking the Future of Cancer Treatment

Application Note
Analysis of ccfmiRNA from Crown Bioscience’s Biobank Plasma Samples

On-Demand Webinar
Biospecimens & Multi-Omics in Clinically Relevant Research

FactSheet
Supercharge Your AML Drug Development

Application Note
The Importance of Tissue Quality for Personalized Medicine

White Paper
PDX Dispatch: Acute Myeloid Leukemia PDX Models

FactSheet
Multi-omics Grade Biospecimens

FactSheet
Immunohistochemistry Services

FactSheet
Drug Profiling Service

FactSheet
Biobank Services

FactSheet
Standard Grade Biospecimes

Application Note
Simple Western Size™, qPCR

Application Note
Drug Profiling Using Human Precision Cut Cancer Tissue Slices

On-Demand Webinar
Longitudinal Plasma Samples: Paving the Way for Precision Oncology

On-Demand Webinar
Biobanking: A Key to Personalized Medicine

On-Demand Webinar
Empowering Cancer Care: The Valuable Impact of Liquid Biopsies

On-Demand Webinar
The Ultimate Guide to PDX Mouse Clinical Trials

Poster
PEGS Europe 2024 Poster A070

FactSheet
PDX Mouse Clinical Trial

On-Demand Webinar
Advanced Imaging Solutions for Orthotopic and Systemic Oncology Models

On-Demand Webinar
Four-Step Preclinical Strategy to Tackle Cancer Drug Resistance

On-Demand Webinar
SynAI: An AI-driven Cancer Drugs Synergism Prediction Platform

On-Demand Webinar
A Novel Approach to Overcoming Limitations of T Cell Immunotherapies

On-Demand Webinar
Effective Preclinical Solutions to Tackle Oncology Drug Resistance

FactSheet
OrganoidXplore™

On-Demand Webinar
Deep Learning Models in Preclinical Histopathology Image Analysis

On-Demand Webinar
What's Next in Preclinical Cancer Immunotherapy Research?

On-Demand Webinar
Analyzing the Suppressive TME in in Vitro Based Assays

On-Demand Webinar
Targeting T Cells Within the Cancer Immunity Cycle

FactSheet
Clinically Aligned Pretreated PDX Models

FactSheet
Nanostring Spatial Multi-omics Services

FactSheet
Data Science and Bioinformatics Services

On-Demand Webinar
Navigating Cancer Model Databases for Optimized Model Selection

FactSheet
Microbiome Sequencing

FactSheet
Pretreated PDX Models

On-Demand Webinar
Preclinical biomarker discovery via in vivo and in vitro screening

On-Demand Webinar
In Vivo Solutions for Oncology Drug Development

On-Demand Webinar
High-Throughput and High-Content Screening in Organoids and 3D Models

FactSheet
Large Scale Cancer Cell Panel Screening

On-Demand Webinar
Patient-Derived Model Systems for Immuno-Oncology Drug Development

FactSheet
Diffuse Large B Cell Lymphoma PDX Models

Application Note
HCC827 NSCLC Cell Line Derived Xenograft Model

Application Note
Drug Discovery in 3D

On-Demand Webinar
Biomarker Discovery for Immune Checkpoint Inhibitors

On-Demand Webinar
Elevate Your Insights into the Tumor Microenvironment

On-Demand Webinar
Clinically Relevant Cell-Based Solutions for Target Identification

On-Demand Webinar
A BiTE-Sized Discussion on Next-Generation Preclinical Models

On-Demand Webinar
Leveraging 3D In Vitro Models for Oncology Drug Discovery

On-Demand Webinar
Shifting the Paradigm of Cancer Treatment: How Can Optical Imaging Help?

On-Demand Webinar
Next Generation Syngeneic Models to Facilitate Immuno-Oncology Research

On-Demand Webinar
How to Leverage Tumor Models for Pancreatic Cancer Research

On-Demand Webinar
How to Detect, Characterize, and Evaluate CAR-T Cell Therapies

On-Demand Webinar
The Ultimate Guide to Mouse Clinical Trials

On-Demand Webinar
Applications of HUB Tumor Organoids in Oncology Drug Discovery

On-Demand Webinar
In Silico Applications for In Vitro Drug Discovery

On-Demand Webinar
Tumor Organoids: A Paradigm Shift in Oncology Drug Discovery

On-Demand Webinar
3D In Vitro Drug Discovery: When and How to Use Tumor Organoids

On-Demand Webinar
Preclinical Prostate Cancer Models: Which One is Right For You?

On-Demand Webinar
Mouse Clinical Trials: The Power Behind Study Design

On-Demand Webinar
In Vitro and Ex Vivo Assays to Accelerate Immuno-Oncology Drug Discovery

On-Demand Webinar
Immuno-Oncology: 3 Strategies for Applying Humanized Models

FactSheet
3D Ex Vivo Patient Tissue Platform

FactSheet
FGFR3 Fusion In Vivo Xenograft Platform

FactSheet
Myeloid Cell Repolarization HCI Assay

FactSheet
3D In Vitro HCI for Immuno-Oncology

White Paper
Advanced Statistical Analyses to Optimize MCTs

FactSheet
CAR-T Therapy

FactSheet
Humanized Target Tumor Cells

FactSheet
Tumor Homograft Models

FactSheet
PDX Model Collection

FactSheet
High Throughput Murine Model Screening

FactSheet
Syngeneic Models

FactSheet
Predictive Biomarkers

Application Note
In Vitro and Ex Vivo Immuno-Oncology Drug Discovery

White Paper
Precision Profiling With PDX

White Paper
The Importance of Using an Isotype Control

White Paper
3 Strategies for Applying Humanized Models

White Paper
How to Choose the Correct I/O Model

White Paper
The Ultimate Guide to Mouse Clinical Trials

White Paper